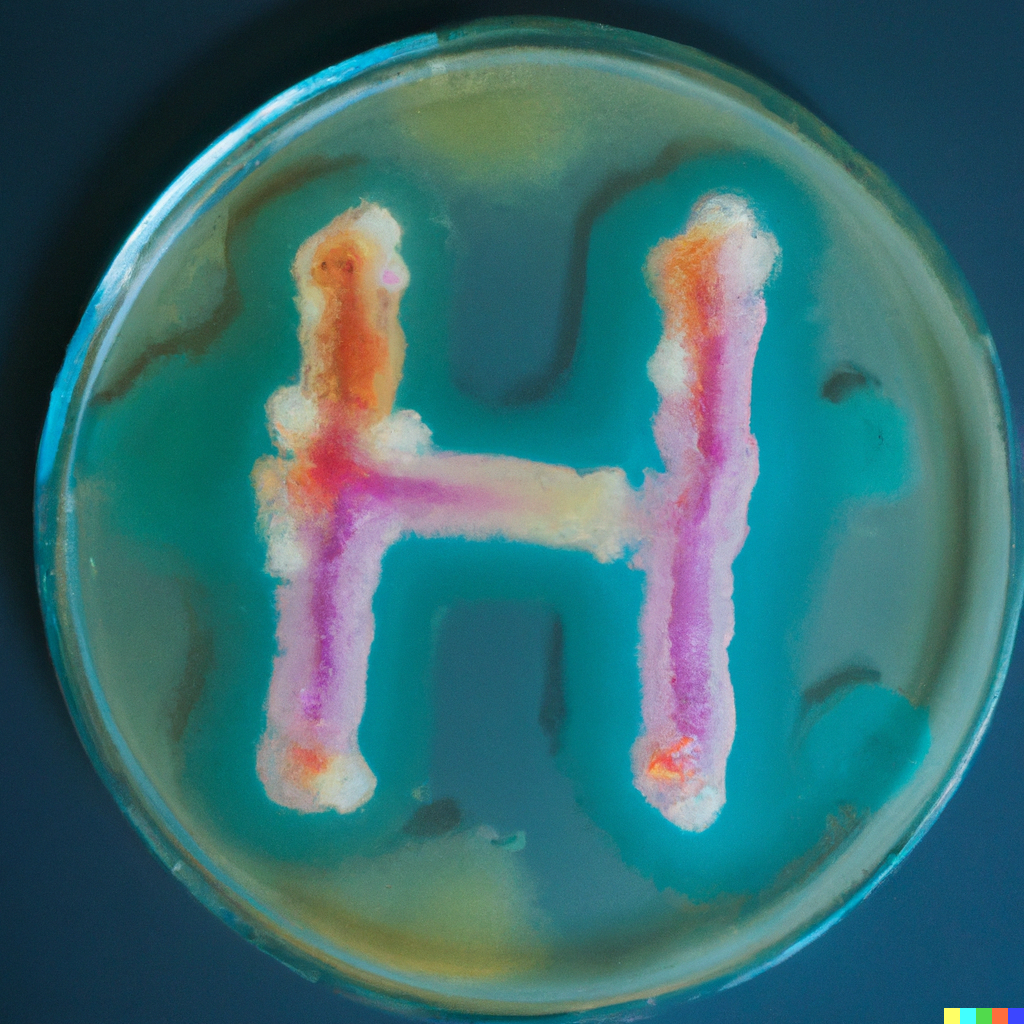
, Nicole Dopffel using DALL-E2, DALL E 2022 08 29 10 43 11 colorful bacteria on an agar plate in the shape of a big H2, ,

Geological hydrogen storage, like today’s natural gas storage, is needed to store variable renewable energies and flexibly provide green hydrogen mobility, industry, and residential uses. The purpose of the EU-funded HyPSTER project is to demonstrate the industrial-scale operation of cyclic H2 storage in salt caverns to support the emergence of the hydrogen energy economy in Europe in line with overall Hydrogen Europe road-mapping. The specific objectives are to:
•Define relevant cyclic tests to be performed based on modelling and the needs of emerging hydrogen regions across Europe
•Demonstrate the viable operation of H2 cyclic storage for the full range of use-cases of emerging European hydrogen regions
•Assess the economic feasibility of large-scale cyclic H2 storage to define the roadmap for future replication across the EU
•Assess the risks and environmental impacts of H2 cyclic storage in salt caverns and provide guidelines for safety, regulations and standards
Microbiological consumption of hydrogen and potential generation of hydrogen sulfide has been identified as one of the potential risks related to hydrogen storage in salt caverns.
Together with Equinor, we in NORCE will address this risk with a microbiological assessment of the cavern brine before and after the hydrogen storage. This will provide valuable information about in-situ microbiological activity after hydrogen exposure over several months. We will further investigate the overall microbial community and how it will be affected by the contact with pure hydrogen over several months. More info about the overall project can be found here: https://hypster-project.eu/